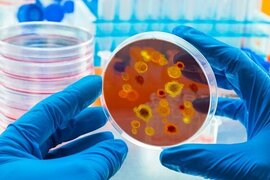
.

Sosial xəbərlər
Qeyri-sabit hava şəraiti nə vaxtadək davam edəcək?
Mayın 12-si saat 11:00-a olan faktiki hava açıqlanıb. Milli Hidrometeorologiya Xidmətindən -a verilən məlumata görə, ölkə ərazisində yağıntılı hava şəraiti müşahidə olunub. Bəzi yerlərdə leysan xarakterli intensiv olub. Belə ki, düşən yağıntının miqdarı Qaxda 36, Şəkidə 19, Göygöl və Şahdağda 8, Qubad
12 may
Sabiq deputat qaynını şirkətindəki vəzifədən azad etdi
Azərbaycanın ən böyük arqoholdinqlərindən sayılan "Karat Holding" MMC-nin direktoru və qanuni təmsilçisi dəyişib. İqtisadiyyat.az-ın əldə etdiyi məlumata görə, Umudov İqdam Əliş oğlu MMC-nin direktoru və qanuni təmsilçisi vəzifəsindən azad olunub. Onun yerinə Xəlilov İlham Şəmil oğlu təyi
12 may
Bu ərazilərə yağış yağıb
Azərbaycanda müşahidə olunan faktiki hava açıqlanıb. Milli Hidrometeorologiya Xidmətindən -a verilən məlumata əsasən, ölkə ərazisində yağıntılı hava şəraiti müşahidə olunub. Bəzi yerlərdə leysan xarakterli yağıntı intensiv olub. Belə ki, düşən yağıntının miqdarı Qaxda 36, Şəkidə 19, Göygöl və Şahdağd
12 may
Gecələr Bakını bir-birinə vuran motosikletçilərə - 15 sutka verildi - Video
Paytaxt ərazisində avtoxuliqanlıq hərəkətləri edən motosiklet sürücüləri həbs edilib. xəbər verir ki, bu barədə Bakı Şəhər DYP İdarəsi məlumat yayıb. Bildirilib ki, Bakı şəhər DYP İdarəsi və Nəsimi RPİ-nin əməkdaşlarının keçirdiyi tədbirlərlə paytaxt ərazisində yol hərəkəti qaydalarını davamlı şəkild
12 may
Alça yığarkən yıxılıb öldü
Dünən Göyçayda ölümlə nəticələnən bədbəxt hadisə baş verib. "Qafqazinfo" xəbər verir ki, 1975-ci il təvəllüdlü Müşfiq Şirinov yaşadığı Bığır kəndində ağacdan alça yığarkən ehtiyatsızlıqdan yıxılıb. O, aldığı xəsarətlər nəticəsində hadisə yerində ölüb. Faktla bağlı Göyçay Rayon Prokurorluğund
12 may
Azərbaycanlı aparıcı efirdə babasının öldüyünü dedi
Aparıcı Zaur Nəbioğluna ağır itki üz verib. xəbər verir ki, onun babası Əvəz Səmədov dünyasını dəyişib. Bu barədə Zaur aparıcısı olduğu "Rəngarəng" verilişində bildirib. Qeyd edək ki, Əvəz Səmədov, Birinci Qarabağ müharibəsi şəhidi Sabir Səmədovun atasıdır
12 may
Azərbaycanda illik ödənişi 9 min manat olan ixtisaslar var - Səbəb nədir?
"Azərbaycanda ali təhsil müəssələrində 7,8, hətta 9 min manata illik təhsil xərcləri olan ixtisaslar var". Bu sözləri "Xəzər Xəbər"ə müsahibəsində təhsil eksperti Rizvan Fikrətoğlu deyib. Onun sözlərinə görə, "Dirijorluq"Bəstəkarlıq"Vokal sənəti", "İnstrumenta
12 may
Tanınmış bloqerlərin reklam etdikləri şirkətə etibar etdilər, aldandılar (VİDEO)
Bakıda bir qrup vətəndaş aldadılıb. Qaynarinfo Xəzər TV-yə istinadən məlumat verir ki, Bakıda vətəndaşlar alqı-satqı şirkətinin "TikTok" reklamlarına inanaraq, mənzil sahibi olmaq ümidi ilə əllərindəki pulları itirdiklərini iddia ediblər. Onların sözlərinə görə, tanınmış bloqerlərin də rekla
12 may
Ağcabədidə külək mağarı uçurdu, toy yarıda qaldı (VİDEO)
Ağcabədidə əsən güclü külək toy mağarını uçurub. "Qafqazinfo"nun xəbərinə görə, hadisə rayonun Aran kəndində baş verib. Kənd sakini Həsənov Qəhrəman oğlu üçün həyətdə qurduğu mağarı külək yararsız hala salıb. Hadisə vaxtı xəsarət alan olmasa da, məclis yarımçıq saxlanılıb
12 may
Çaylarda sululuq artıb
Çaylarda müşahidə olunan faktiki vəziyyət açıqlanıb. xəbər verir ki, bu barədə Milli Hidrometeorologiya Xidməti məlumat yayıb. Bildirilib ki, avtomat hidroloji stansiyaların mayın 11-i saat 9:00-a olan məlumatına əsasən, bəzi çaylarda sululuq artıb. Böyük Qafqaz ərazisindən axan Qusarçayda 13 sm, Əyriçayd
11 may
Qeyri-sabit hava şəraiti nə vaxtadək davam edəcək?
Ölkə ərazisində müşahidə olunan qeyri-sabit hava şəraiti davam edir. xəbər verir ki, bu barədə Milli Hidrometeorologiya Xidmətindən məlumat verilib. Qeyd edilib ki, ölkə ərazisində müşahidə olunan qeyri-sabit hava şəraiti mayın 15-i axşamadək davam edəcək
11 may
Vətəndaşların NƏZƏRİNƏ: Qiymətlər 5 dəfə artdı- Ötən həftə 1 manat idi
"Qobustan qoruğuna giriş biletlərini kəskin bahalaşdırıblar". -a istinadla xəbər verir ki, bunu iqtisadçı Natiq Cəfərli qeyd edib. İqtisadçının sözlərinə görə, əvvəllər yerli ziyarətçilər üçün qiymət 4, əcnəbilərə 10, tələbələrə 1, məktəblilərə isə 0.40 AZN olub:. "Bir neçə gün öncə yen
11 may
11 yaşlı qıza qarşı əxlaqsız edən ilahiyyatçı ilə bağlı YENİ DETALLAR
Yetkinlik yaşına çatmayan qıza qarşı əxlaqsız hərəkətlər etməkdə təqsirləndirilərək 3 il 9 ay müddətinə azadlıqdan məhrum edilmiş ilahiyyatçı Salman Kamiloğlunun cinayət işinin təfərrüatı məlum olub. Onun ifadəsindən hadisənin bilinməyən məqamları üzə çıxıb. -a istinadən xəbər verir ki, Cinayət Məcəlləsini
11 may
Əhaliyə CİDDİ XƏBƏRDARLIQ - Diqqətli olun, gələn həftə…
May ayında Yer kürəsində bir sıra maqnit qasırğaları müşahidə olunacaq. xəbər verir ki, bu hadisələr Günəşdə baş verən partlayışlar və tac kütləsinin atılması nəticəsində yaranır, nəticədə Yerə çatan yüklü hissəciklər planetin maqnit sahəsində pozuntulara səbəb olur. Bu cür geomaqnit aktivliklər, xüsusil
11 may
Hava ilə bağlı XƏBƏRDARLIQ! Bakıda və rayonlarda yağış, sulu qar...
Mayın 12-də Bakıda və Abşeron yarımadasında hava şəraitinin dəyişkən buludlu olacağı, arabir tutulacağı, əsasən yağmursuz keçəcəyi gözlənilir. Bu barədə -a Milli Hidrometeorologiya Xidmətindən bildirilib. Səhər bəzi şəhərətrafı ərazilərdə qısamüddətli az yağış yağacağı ehtimalı var. Mülayim şimal-qər
11 may
DYP-dən piyadalara ÇAĞIRIŞ
Mayın 12-dən 19-dək respublika ərazisində "Piyadalar, diqqətli olun!" şərti adı altında hərəkətin təhlükəsizliyi həftəliyi keçiriləcək. Baş Dövlət Yol Polisi İdarəsindən -a bildirilib ki, tədbir çərçivəsində piyadalar tərəfindən yol hərəkəti qaydalarının pozulması hallarına qarşı nəzarət-profilakti
11 may
Çay idxalı aşağı düşəcək: Qiymət qalxacaq?
Azərbaycan çayı həm adı, həm də dadı ilə dünya bazarında tanınır. Bu səbəbdən ölkəmizdə istehsal olunan çay xarici ölkələrdə böyük rəğbət qazanıb. Astara sakini Ağaməmməd Məlikov ötən il 75 ton məhsul yığdıqlarını, bu il isə daha çox məhsul gözlədiklərini bildirib. Onun sözlərinə görə, ölkəmizdə çayı
11 may
Üç əsrin şahidi: Qubadakı tarixi körpünü özəl edən səbəblər nələrdir?
XIX əsrdə Quba qəzasında 7 körpü olub. Onlardan yalnız biri - Tağlı körpü bu günə qədər qorunub saxlanılıb. 3 əsrə şahidlik edən, Qudyalçay üzərində inşa edilən tikili Quba şəhərinin mərkəzi ilə Qırmızı qəsəbəni birləşdirir. Tarixçi Rüfət Mürsəlovun sözlərinə görə, ilk dəfə taxtadan tikilən körpü zamanl
11 may
Mərkəz və qəsəbə bazarlarında nə qədər qiymət fərqi var? - VİDEO
Bakı qəsəbələrinin ucuz bazarları. Hətta bu bazara digər qəsəbələrdən gələn alıcılar da var. Xəzər TV-yə istinadən bildirir ki, alıcılar deyir ki, cüzi fərqlə Maştağa bazarından baha olan bu bazar yenə də paytaxtın mərkəzində yerləşən bazarlardan sərfəlidir. Şəhərin mərkəzindəki qiymətlərdə də maraqlandıq
11 may
Vəfat edən şəxsin pensiyasını BU ŞƏXSLƏR DƏ ALA BİLƏCƏK - VİDEO
Mövcud qanunvericiliyə əsasən, bəzi hallarda dünyasını dəyişən şəxsin topladığı pensiya kapitalı və ya aldığı pensiya vərəsələrinə verilə bilər. -ın xəbərinə görə, millət vəkili Vüqar Bayramov deyir ki, bu hüquq əsasən 18 yaşına çatmayan övladlara, əlilliyi olan şəxslərə və dünyasını dəyişən şəxsin həya
11 may
İlham Əliyev şəhid atalarının dəstəyindən danışarkən kövrəldi - VİDEO
Prezidenti İlham Əliyevin Ağdam rayonunun Kəngərli kəndinə köçən sakinlərlə söhbəti zamanı duyğulu anlar yaşanıb. "Xalq arxamda durmasaydı, əgər müharibə dövründə hər hansı bir tərəddüd hiss olunsaydı, yaxud da ki, cəmiyyətdə hər hansı bir fikir ayrılığı olsaydı, bu Qələbəni belə şəraitdə, bel
11 may
Qonşu ölkədə təhlükəli virusla bağlı XƏBƏRDARLIQ - Nazirlik əhaliyə ÇAĞIRIŞ ETDİ
İranın səhiyyə nazirinin müavini Əlirza Rəisi ölkədə yeni koronavirus infeksiyası dalğası barədə xəbərdarlıq edib. xəbər verir ki, bu barədə "Azad İran" telegram kanalı məlumat yayıb. Nazir müavini insanları bir daha maskalardan istifadə etməyə çağırıb. O, həm də ictimaiyyətin məlumatlandırılmasınd
11 may
Ağasən Bədəlzadə VƏFAT ETDİ - FOTO
Azərbaycan Yazıçılar Birliyinin üzvü, tanınmış şair, filologiya üzrə fəlsəfə doktoru, dosent Ağasən Bədəlzadə vəfat edib. Bu barədə şairin oğlu Səbuhi Bədəlov məlumat verib. O bildirib ki, Ağasən Bədəlzadə bu gün 85 yaşında dünyasını dəyişib. Xatırladaq ki, artıq bir neçə ildir insult keçirmiş şair ö
11 may
Pomidor sürətlə ucuzlaşacaq – BU TARİXDƏN
Xəbər verdiyimiz kimi Türkmənistandan idxal edilən pomidor məhsulundan nümunələr götürülərək müayinələrə cəlb olunub. Azərbaycan Qida Təhlükəsizliyi Agentliyindən (AQTA) verilən məlumata görə nümunələrin laborator müayinəsi nəticəsində 11 məhsul partiyasında pomidor meyvələrinin qonur qırışıqlıq virus
11 may
Azərbaycanda BU DİL SÜRƏTLƏ YAYILIR - Orta məktəblərdə tədris olunacaq?
Xəbər verdiyimiz kimi, aprelin 23-də Azərbaycan Prezidenti İlham Əliyevin Çin Xalq Respublikasına səfəri baş tutub. Səfər çərçivəsində hər iki ölkənin dövlət başçılarının iştirakı ilə Azərbaycanla Çin arasında müxtəlif sahələrdə əməkdaşlığı ehtiva edən bir sıra mühüm sənədlər imzalanıb. İki ölkə arasındak
11 may
Mehriban Əliyeva İlham Əliyevlə Ağdama səfərdən GÖRÜNTÜLƏR PAYLAŞIB - VİDEO
Birinci vitse-prezident Mehriban Əliyeva rəsmi "İnstagram" hesabında Prezident İlham Əliyevlə Ağdama səfərdən görüntülər paylaşıb. xəbər verir ki, paylaşımda deyilir:. "Yolun hər zaman açıq və işıqlı olsun, doğma Azərbaycan
10 may
Səməd Seyidov: "Pakistan bizim yaxın dostumuzdur"
"Azərbaycan və Pakistan arasındakı dostluq münasibətləri davam etdiriləcək və möhkəmləndiriləcək". xəbər verir ki, bu sözləri deputat Səməd Seyidov jurnalistlərə açıqlamasında deyib. O bildirib ki, Azərbaycan haqqın, ədalətin tərəfində dayanıb və bu nöqteyi nəzərdən Azərbaycanın mövqeyini artı
10 may
Prezident İlham Əliyevin Ağdama səfərindən SƏMİMİ GÖRÜNTÜLƏR- VİDEO
Azərbaycan Respublikasının Prezidenti İlham Əliyevin sosial şəbəkə hesablarında Ağdamda Muğam Mərkəzinin açılış mərasimindən görüntülər paylaşılıb. xəbər verir ki, görüntülərdə dövlət başçısı və birinci xanım Mehriban Əliyeva Muğam Mərkəzinin açılış mərasimindən sonra ictimaiyyət nümayəndələri ilə görüşü
10 may
Ceyhun Bayramov: "Mart ayında sülh sazişi mətni üzərində danışıqlar yekunlaşıb"
"Mart ayında sülh sazişi mətni üzərində danışıqlar yekunlaşıb". xəbər verir ki, bunu jurnalistlərə açıqlamasında xarici işlər naziri Ceyhun Bayramov deyib. O bildirib ki, Azərbaycan tərəfinin qarşı tərəfdən gözləntiləri var:. "Bu, Konstitusiya dəyişikliyi və ATƏT-in Minsk qrupunun ləğvidir
10 may
Ceyhun Bayramov: "2020-ci ildən partlayışların hamısı mina xəritəsi təqdim edilməyən yerlərdə olub"
"Mina xəritələrinin təqdim olunmasında Ermənistan qeyri-ardıcıl davranış nümayiş etdirib". xəbər verir ki, bu sözləri xarici işlər naziri Ceyhun Bayramov jurnalistlərə açıqlamasında deyib. O bildirib ki, öncə mina xəritələrinin mövcudluğunu inkar edən Ermənistan beynəlxalq təzyiqlər nəticəsind
10 may
"2026-cı il Azərbaycanda böhranın başlanğıcı olacaq"- iqtisadçı NATİQ CƏFƏRLİ
Vüqar Əhməd saxlanılıb? - Özü danışdı+Yenilənib
Azərbaycan Universitetində bədbəxt hadisə
Bəzi yerlərdə yollar buz bağlayacaq - Xəbərdarlıq
Sonsuz yalan danışırlar: Xroniki yalançıların 11 vərdişi
Vardanyanın məhkəmə istintaqı yekunlaşdı
İcra başçısı baş mütəxəssisi işdən çıxardı
Yeni ildə bu rəngləri geyinməyin: onlar xoşbəxtliyi, pulu və sevgini uzaqlaşdırır
Dünyada ən sürətli heyvan hansıdır?
Bəylər Eyyubovun general qardaşı oğlu işdən çıxarıldı
Əmək müqaviləsinə xitam verilməsi ilə bağlı şərtlər dəyişdi
Rüşvət verib "sertifikatlar" alan plastik cərrahlar - Üzərində "ölüm işi" olan da var
Milli Məclisin plenar iclası başlayıb, gündəlikdə 10 məsələ var
"Yerdəki 100 manatı götürmək istəyəndə yıxıldı" - Video
Dünyanın ən ağır binası hər il altı millimetr dərinə gedir
